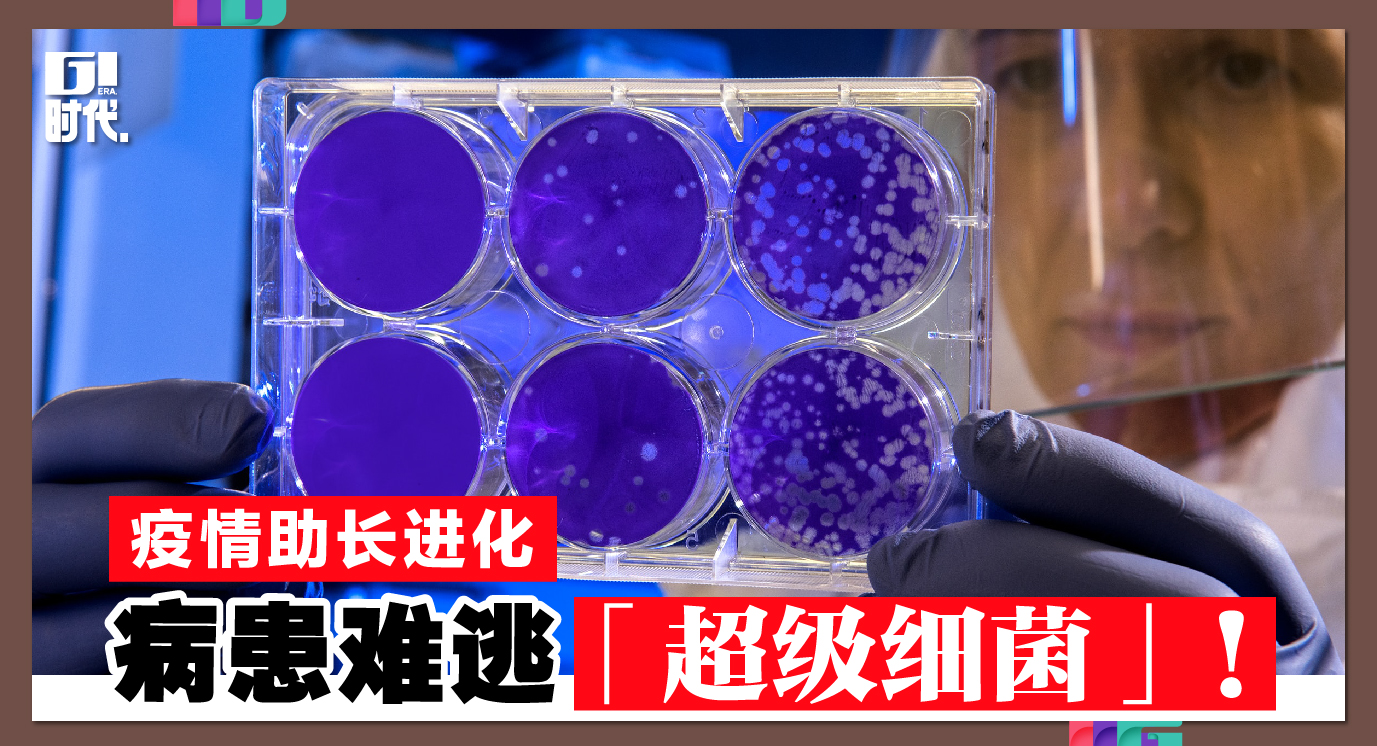
Content_design_finalpick0719-05-01

联邦疾病防治中心日前表示,新冠疫情大幅助长超级细菌感染的病例,死亡人数也激增,逆转了人类在现代公卫领域的进步。
疾防中心的分析报告说,新冠初袭的2020年主要超级细菌的感染与死亡人数都比2019年增加15%;其中,最抗药、会导致血管与尿道感染的超级细菌致病人数飙升78%。报告分析的重点是美国抗药病菌,特别是源自医院的超级病菌发展、扩散的情况。
新冠病疫初期,医护人员不明新冠病毒底细,给发高烧、呼吸急促的病患大量服用抗生素,2020年3月到10月就诊的患者80%都服用了抗生素,这些救命良药却是对付病菌,不是对付病毒的,对病患造成副作用不算,还让一般病菌提升了抗药性,加速其扩散,成为超级病菌。
人员短缺,器材不足,特别是高品质的N95防护口罩不够,防护不足的医疗人员还得照护新冠病患,造成这种双重风险状况:保护不了自己的医疗人员,硬着头皮照顾可能感染别人的患者。
CDC超级病菌防治组领导人史瑞尼瓦衫说,新冠病毒不仅对数百万新冠患者和上百万死者造成冲击,也对美国医院裡的病人安全造成深远影响。
他说,有些病患逃过新冠一劫,好不容易从病毒侵袭康复了,却走到「更恐怖」的一步,死于抗药病菌的感染。
报告说,2020年2万9400人死于抗药病菌感染,其中40%是在医院感染。
【免责声明】本网站欢迎网民与用户发表建设性留言,目的在于互动与交流,并不代表本网赞同其观点和对其真实性负责,也非本网站立场,任何人身攻击、鼓吹种族宗教隔阂、诽谤造谣、网络霸凌、抹黑等煽动性留言,本网站有权删除违规留言。
天才是百分之一的灵感,百分之九十九的汗水。—— 爱迪生
”以一元店模式崛起 宜购百货李家发晋身富豪榜
随着宜购百货于去年5月成功上市,其创办人兼董事经理拿督斯里李家发的身家同步攀升,首次跻身《福布斯》马来西亚富豪榜。
以一元店模式崛起 宜购百货李家发晋身富豪榜
随着宜购百货于去年5月成功上市,其创办人兼董事经理拿督斯里李家发的身家同步攀升,首次跻身《福布斯》马来西亚富豪榜。
飞机起降时打开遮光板 关乎飞行安全
如果你曾搭乘飞机,应该会发现一个看似不起眼却反覆被提醒的细节:在飞机起飞、降落,甚至滑行时,空服员都会要求坐在窗边的乘客把窗户遮光板打开。这个规定并不是为了让乘客欣赏风景,而是与飞行安全息息相关。
外卖员去白宫送快餐 特朗普打赏百元小费
日前,一名年逾六旬的外送员谢龙·西蒙斯,手提两袋麦当劳餐点,按响了白宫椭圆形办公室的大门。美国总统特朗普亲自应门,将这次外送变成一场即兴却巧妙的公共沟通场景。
Mesra便利商店 连4年销售破10亿
国油贸易正加速摆脱对传统燃油业务的依赖,旗下Mesra便利商店持续成为非燃油收入的重要引擎,连续4年录得超过10亿令吉销售额,展现稳健增长动能。
误加17倍辣椒「劲辣酱料」竟大卖 失魂员工变业绩王
有时“错有错着”,反而能成就意想不到的惊喜。日本岩手县一家酱油厂近日推出一款名为“小林调错比例的17倍辣味烤肉酱”,凭借独特的诞生故事与强烈口感,迅速吸引市场关注,成为嗜辣族群热议的新品。










